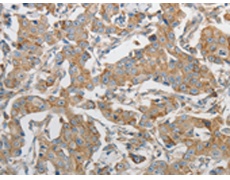
一抗

中文名稱: 兔抗PRMT5多克隆抗體
英文名稱: Anti-PRMT5 rabbit polyclonal antibody
別 名: JBP1, SKB1, IBP72, SKB1Hs, HRMT1L5
相關(guān)類別: 一抗
儲 存: 冷凍(-20℃)
宿 主: Rabbit
抗 原: PRMT5
反應種屬: Human, Mouse, Rat
標 記 物: Unconjugate
克隆類型: rabbit polyclonal
技術(shù)規(guī)格
|
Background: |
Protein arginine methyltransferase 5 has been shown to interact with WD repeat-containing protein 77, CLNS1A, Janus kinase 2, SNRPD3 and SUPT5H.Arginine methyltransferase that can both catalyze the formation of omega-N monomethylarginine (MMA) and symmetrical dimethylarginine (sDMA), with a preference for the formation of MMA. Specifically mediates the symmetrical dimethylation of arginine residues in the small nuclear ribonucleoproteins Sm D1 (SNRPD1) and Sm D3 (SNRPD3); such methylation being required for the assembly and biogenesis of snRNP core particles. Methylates SUPT5H. Mono- and dimethylates arginine residues of myelin basic protein (MBP) in vitro. Plays a role in the assembly of snRNP core particles. May play a role in cytokine-activated transduction pathways. Negatively regulates cyclin E1 promoter activity and cellular proliferation. |
|
Applications: |
ELISA, WB, IHC |
|
Name of antibody: |
PRMT5 |
|
Immunogen: |
Synthetic peptide of human PRMT5 |
|
Full name: |
protein arginine methyltransferase 5 |
|
Synonyms: |
JBP1, SKB1, IBP72, SKB1Hs, HRMT1L5 |
|
SwissProt: |
O14744 |
|
ELISA Recommended dilution: |
1000-2000 |
|
IHC positive control: |
Human breast cancer and Human tonsil |
|
IHC Recommend dilution: |
15-50 |
|
WB Predicted band size: |
71 kDa |
|
WB Positive control: |
K562, hela and 293T cells |
|
WB Recommended dilution: |
200-1000 |


 購物車
購物車 幫助
幫助
 021-54845833/15800441009
021-54845833/15800441009